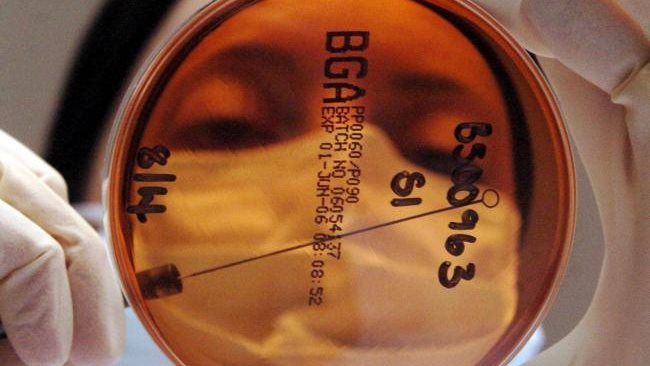

كشفت دراسة جديدة أجريت مؤخرا عن تأثير بكتيريا الأمعاء على الخلايا السرطانية من قبل باحثون بريطانيون معهد أبحاث السرطان في لندن، إلى أن بكتيريا الأمعاء الشائعة يمكن أن تغذي نمو الأورام لدى مرضى سرطان البروستاتا وتسمح لهم بالتهرب من آثار العلاج.
تأثير بكتيريا الأمعاء على انتشار الأورام السرطانية
وتابع الباحثون المشرفون على الدراسة، أنه عادةً ما يُعالج سرطان البروستاتا بالعلاج الهرموني ، والذي يعمل عن طريق تثبيط هرمونات الذكورة التي تسمى الأندروجينات، وفقا لما نشر في صحيفة “ديلي ميل” البريطانية .
ووجد العلماء البريطانيين، أن انخفاض مستويات الأندروجين يمكن أن يؤدي إلى توسع بكتيريا الأمعاء ، والتي يمكنها بعد ذلك "السيطرة" على إنتاج الهرمون؛ حيث ان "البصمات البكتيرية" قد تساعد في تحديد مرضى السرطان الذين سيصبح لديهم مقاومة من العلاج.
ويقترح الباحثون، أن هؤلاء الرجال يمكن أن يستفيدوا من استراتيجيات التعامل مع ميكروبيوم أمعائهم؛ حيث يمكن أن يخضع الرجال لعملية زرع البراز أو يأمل الباحثون في إنتاج مشروب زبادي غني بالبكتيريا المفيدة.
ويقتل سرطان البروستاتا 11800 رجل سنويا في بريطانيا ، أي ما يعادل رجل كل 45 دقيقة ، و 26 ألف رجل في الولايات المتحدة كل عام، وقال مؤلف الدراسة وأستاذ طب السرطان التجريبي يوهان دي بونو، أنه تكشف نتائجنا أن بدء العلاج الهرموني لسرطان البروستاتا يمكن أن يؤدي إلى بدء إنتاج هرمونات الأندروجين.

واوضح بونو، أنه يمكن لهذه الأندروجينات أن تحافظ على نمو سرطان البروستاتا وتزيد من مقاومة العلاج الهرموني، مما يؤدي إلى تدهور نتائج بقاء الرجال؛ حيث أن هناك حاجة إلى مزيد من البحث ، فإن هذا الاكتشاف يمكن أن يؤدي إلى علاجات جديدة تتعامل مع بكتيريا الأمعاء تعمل لصالح المرضى.
وأكد الباحثون، أنه يمكن صناعة مشروب زبادي مع بكتيريا حية لا تنتج هرمونات تغذي السرطان ، أو زرع براز من شخص آخر مصاب ببكتيريا الأمعاء مختلفة؛ حيث ان زرع البراز هو نقل البراز من المتبرع إلى الجهاز الهضمي للمريض، وهو الأكثر شيوعًا؛ حيث تكون فعالة بنسبة 90 في المائة.
وتعد بكتيريا الأمعاء جزءًا من الميكروبيوم لدينا ، وهي مجموعة من الكائنات الحية الدقيقة التي تعيش عادة في الجسم ، وعادة ما تكون ذات قيمة للإنسان من خلال المساعدة على الهضم، ومع ذلك ، يمكن للسرطان والأمراض الأخرى أن تدمر هذا التوازن، من خلال تعزيز انتشار بكتيريا الأمعاء وتشجيعها على إطلاق السموم أو الجزيئات الأخرى التي تؤثر على الخلايا السرطانية.
ووجدت الدراسة، أن التخلص من جميع بكتيريا الأمعاء في الفئران المصابة بسرطان البروستاتا يبطئ نمو الورم ويؤخر ظهور مقاومة الهرمونات، وكشفت أيضًا أن زرع البراز من الفئران المصابة بسرطان البروستاتا المقاوم للهرمونات في الفئران ذات مستويات الأندروجين المنخفضة التي لم تطور مقاومة شجع نمو الورم.